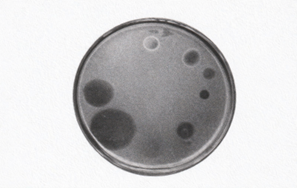

「ウイルスは生物か」という論争は、タバコモザイクウイルスが結晶として得られてもなお感染性を保つことをウェンデル・スタンレーが報告した1930年代に、ひとつの決定的な形をとった。日本では1956年、川喜田愛郎が名著『生物と無生物の間』でこの問題を詳しく解説しているが、ちょうどその年、私はウイルス研究の世界に足を踏み入れた。それ以来、この問いは70年間、私の脳裏を離れなかった。
ただ最近になって、ひとつの偏りに気づいた。生物界には真核生物(動物・植物・菌類)、細菌、アーキアという3つのドメインがあるのに、「生物」の像は長いあいだ、事実上そのうち2つ——真核生物と細菌——の経験から形づくられてきたのである。
今回は、3つのドメインの生物を視野に入れて、改めて「ウイルスは生物か」を考えてみたい。
I 生命と生物のあいだ
Lifeという一語が隠しているもの——名詞ではない生命
「生命」も「生物」も、英語では同じlifeである。しかし日本語では、この二つは明確に使い分けられている。生命は抽象的で、原理的で、しばしば哲学的な響きを帯びる。一方、生物は具体的で、観察され、分類され、研究対象として切り分けられる存在である。この言葉のズレそのものが、「生命とは何か」を考えるための、きわめてよい入口になっている。
まず、「生物(living being)」とは何か。生物は、生物学的・分類学的には比較的はっきり定義される。一般に、生物は次のような性質を持つとされている。代謝を行い、自己複製し、変異と選択によって進化する。外界と自らを隔てる境界——膜や殻——をもち、環境の変化に応答する。これらは比較可能で、体系的に整理できる性質である。
この枠組みの中でこそ、「ウイルスは生物か」という問いが生じる。ウイルスは代謝をもたず、宿主なしには自己複製できない。進化はするが、細胞という単位を欠く。このため、生物の定義から外れる――少なくとも、外れかけた存在として扱われてきた。
では、「生命(life)」とは何か。生命は、生物のように対象としてそこに置けるものではない。むしろそれは、状態であり、過程であり、原理である。生命は、「自己を維持しながら変化し続ける過程」であり、「エネルギーと情報の流れが秩序を生み出す現象」であり、さらに言えば、「死に向かって進行する不可逆な時間構造」として捉えられる。ここで生命は、もはや“もの”ではなく、“起きていること”を指している。
この発想は、実は古代から萌芽していた。アリストテレスは生命を「魂(プシュケー)をもつもの」と定義したが、この魂は宗教的な実体ではない。栄養する魂、感覚する魂、理性をもつ魂という、機能の階層を指していた。生命とは、ある特定の物質ではなく、機能の集合体であるという見方が、すでにそこにある。
近代に入ると、生命観は大きく揺れ動いた。19世紀まで、生命には特別な「生気(vital force)」があるのではないかと考えられていた。だが20世紀に入り、DNA、酵素、代謝回路といった分子機構が次々に解明されるにつれ、生気論は否定されていった。生命は、特別な力ではなく、物理化学的過程の組み合わせとして説明できるようになった。
しかし皮肉なことに、すべてを分子で説明できるようになっても、「生命そのもの」を定義することは、かえって難しくなった。分解すれば理解できるが、統合すると何かがこぼれ落ちる。この違和感は、生命が単なる物質の総和ではないことを、逆説的に示している。
現在、比較的広く共有されている理解は、生命を「境界をもつプロセス」と捉える考え方である。生命とは、境界をもち、外界と物質・エネルギー・情報を交換しながら、自己を一時的に維持するプロセスである。この視点に立つと、細胞は生命の単位であり、個体はその一時的な構造にすぎず、種は情報の連続体として理解される。
ここで改めて、日本語が「生命」と「生物」を分けてきた意味が浮かび上がる。生物は観察でき、測定でき、分類できる。一方、生命は意味や価値、時間的連続性を含む概念である。「生命倫理」(bioethics),「生命の尊厳」(dignity of life)「生命史」(life history)といった言葉が指す生命は、単に biological organism という語で言い換えられるものではない。日本語は、life がもつ二重性——対象としての側面と、原理としての側面——を、言語の中に自然に書き分けてきたのである。
短く言えば、生物とは「生命が宿っている構造」であり、生命とは「その構造を成り立たせている流れ」である。生命は名詞ではなく、動詞に近いとも言える。私たちは生命を「持つ」のではなく、生命を「している」存在というわけである。(1, 2)
生物の世界は3つの系統から成り立つ——リボソームという年代記
1960年代、微生物学の常識は「生命は中温、中性環境で生きる」という暗黙の前提に支えられていた。この前提を現場から揺さぶったのは、米国ウイスコンシン大学の微生物学者トーマス・ブロックだった。1967年、米国イェローストーン国立公園の間欠泉での現地調査の際、ブロックは、78℃で増殖する細菌を分離し、サーマス・アクアティカスと名づけた。さらに1972年には、イェローストーン国立公園の別の間欠泉から85℃で増殖する細菌を分離し、スルフォロブス・アシドカルダリウスと名づけた。この名前は、「葉っぱのような(lobe)な形で、硫黄(sulfur)を含み高温(caldus)で酸性(acid)の環境に住む」という意味である。これは、高温を本来の生態ニッチとする生物の実在を示したものである。ここで重要な点は、生命の限界が、理論ではなく、環境から再定義されたことである。(3)
生命が極限環境に存在するという事実は、生物の分類学そのものに新たな問いを投げかけた。1970年代、米国イリノイ大学の生物物理学者カール・ウーズは、この問いに応える決定的な方法論を見いだした。それまでの分類学は、形態、整理、代謝様式に依存していた。しかし、微生物の世界では、形態の多様性は乏しく、代謝は環境によって容易に変化する。適応は語れても、系統は語れなかった。ウーズが求めたのは、すべての生物に共通し、生命の根幹を担い、機能上は保存されながら、配列としてはゆっくり変化する、進化の履歴を刻み込んだ分子だった。そこで取り上げたのはタンパク質合成装置としてのリボソームである。リボソームは、すべての生命に必須であり、生命が生命であるための最小条件に近い存在である。とりわけリボソームRNAは、遺伝情報をタンパク質に翻訳するという中枢機能を担うため急激な変化が許されないが、完全に不変というわけではなく、時間とともに差異が蓄積するという、系統解析にとって理想的な性質を備えていた。代謝酵素は水平伝播しやすく、環境適応の影響を強く受けるが、リボソームRNA は水平伝播に対して頑健で、比較的忠実に保存されている。ウーズにとって、リボソームとは、生命が誕生して以来、連綿と受け継がれてきた分子の年代記だったのである。
ウーズは酸素が存在しない沼地の底などで増殖するメタン産生菌のリボソーム RNAの遺伝子構造を調べたところ、ほかの細菌とはかなり異なることに気づき、1977年、「古細菌(アーキバクテリア)」と命名した。1978年には塩田や塩水湖で増殖する高度好塩菌が、1979年にはブロックが分離していた超好熱菌が古細菌の仲間に加えられた。
古細菌の配列は、既知の細菌からも、また真核生物(動物・植物・カビ)からも、等距離に離れていて、それは「変わった細菌」では説明できない差異だった。一方、ドイツ・マックスプランク研究所の生化学者ヴォルフラム・ジリッヒは1979年、超好熱菌のRNA合成酵素が細菌の酵素よりも複雑で真核生物に近いことに気が付いた。これらの結果から、ウーズは、古細菌を細菌とは別の系列の生物と判断し、1990年、生物界を真核生物、細菌、アーキアという3つのドメインに分類した。 アーキアという名前は、古代ギリシア語で「古代」または「原始」を意味する「アルカイオ」に由来する。(4, 5)
この3ドメイン説は、分類表の書き換えにとどまらない意味を持つ。生命は、われわれが慣れ親しんできた環境条件に合わせて進化したのではない。むしろ、地球のあらゆる環境に適応しながら、多様な形で存続してきた。その事実が分子のレベルで示されたのである。(6)
アーキアの発見は、生命の「例外」を集めた話ではない。それは、生命とは何かを考える基準そのものを広げる出来事だった。極限環境は、生命の周縁ではなく、もう一つの中心だったのである。そしてこの舞台に、もう一人の主役——ウイルス——が登場する。
アーキアウイルスの発見——極限は周縁ではない
アーキアウイルスの物語は、1974年にさかのぼる。ノルウェーの微生物学者トルスヴィークは、塩分濃度15%を超える高塩湖に生息する好塩菌 ハリナバクテイウム・サリナルム の細胞内に、ウイルス様粒子が存在することを報告した。当時、この微生物は「細菌」の一種と考えられており、そこで見つかった粒子も、当然のように細菌ウイルス(ファージ)と解釈された。しかしこの発見は、のちに思いがけない意味を帯びることになる。
1970年代後半、前述のようにウーズによって、生物は真核生物・細菌・アーキアという三つのドメインに再編された。好塩菌は細菌ではなく、アーキアに属することが判明したのである。こうして1974年の観察は、結果としてアーキアウイルスの最初の発見として位置づけられることになった。
決定的な転機は1980年代初頭に訪れる。ジリッヒは、「古細菌にも固有のウイルスが存在するはず」という仮説のもと、極限環境に目を向けた。1982年、彼は別府温泉の高温・強酸性泉(pH2–3、80℃前後)から、好熱・好酸性アーキアスルフォロブス・シバタエに感染する未知のウイルスを分離することに成功する。(3, 7)
そのウイルスは、従来知られていたファージとはまったく異なる、紡錘形——レモンのような独特の形をしていた。ジリッヒはこれをスルフォロブス・スピンドル型ウイルス(SSV)と名づけた。この発見は、単に「珍しい形のウイルス」が見つかったという話ではない。高温・強酸性という、従来はウイルスが安定して存在できないと考えられていた環境において、ウイルスが宿主と共存し、増殖しているという事実を突きつけたのである。
その後、SSVに代表される超好熱アーキアウイルスは、アイスランド、イタリア、ロシア、アメリカなど、世界各地の火山温泉から次々に分離されていく。これらの多くは、60〜90℃という高温、pH2〜3の強酸性環境下で安定に増殖する。極限環境は、もはや生命の「実験場」ではなく、ウイルスと宿主が長い進化史を共有してきた、生態系そのものだった。
興味深いことに、アーキアウイルスは過酷な自然環境だけに存在するわけではない。私たちの腸内にも、メタン生成アーキアに感染する多数のウイルスが存在していることが、近年のメタゲノム解析によって明らかになってきた。体内ヴァイロームの一部として、アーキアウイルスは人間という生態系の内部にも静かに組み込まれているのである。(8)
これまでの約40年間で、分離・記載されたアーキアウイルスは117種以上にのぼる。数だけを見れば、6000種以上が知られるファージに比べて少ない。しかし、その形態的・構造的多様性は際立っている。現在までに分類された29のアーキアウイルスは、実に15のウイルス科に分けられている。一方、膨大な数のファージは、わずか10のウイルス科に収まり、その96%は尻尾をもつカウドウイルス目に属している。
図 アーキアウイルスの多様な形
(SSVはフセロウイルス科)
この対照は示唆的である。数ではなく「かたち」の多様性——そこに、アーキアウイルスの本質がある。アーキアウイルスは、既存のウイルス進化の延長線上にある存在ではない。それは、生命とウイルスの関係そのものが、私たちの想像以上に多様でありうることを、極限環境と体内世界の両端から教えてくれる存在なのである。
ウイルスは生命ではないのか——生命を「コードするもの」から考え直す
生物の世界は、長いあいだ「生きものは皆、同じ系統の延長線上にある」という暗黙の前提のもとで理解されてきた。しかし20世紀後半、この前提は根底から覆される。分子生物学的手法を用いて生命の進化を読み解いた結果、生物の世界は3つの根本的に異なる系統——細菌、アーキア、真核生物——から成り立っていることが明らかになったのである。
この3ドメイン論は、見た目や生活様式ではなく、リボソームRNAという生命の根幹装置の分子構造に基づいて構築された。すなわち、3ドメインとは「細胞をもつ生命がどのように分岐してきたか」を描いた、極めて精密な進化の地図である。
重要なのは、この地図が「生命のすべて」を対象にしたものではないという点である。3ドメイン論は、細胞をもつ生命を厳密に定義し、その内部構造を描き切ることに成功したが、細胞をもたない存在——すなわちウイルス——は、最初からその射程外にあった。
したがって、ウイルスが3ドメインに含まれていないのは、例外扱いされたからでも、軽視されたからでもない。3ドメインとは、細胞生命を理解するための理論的枠組みであり、その完成度の高さゆえに、逆に「この枠組みでは語れない存在」が明確になったのである。
では、その語れない存在であるウイルスは、生命ではないのだろうか。この問いに対して、長らく教科書的な答えは「否」であった。ウイルスは細胞構造をもたず、自らエネルギーを生み出す代謝を行わず、宿主の細胞に依存しなければ増殖できない。こうした特徴は、生命の定義からウイルスを外す十分な理由とされてきた。
しかし、この答えにはどこか割り切れないものが残る。なぜなら、ウイルスは明らかに進化するからである。変異を起こし、選択を受け、環境に適応しながら系統を分岐させていく。この「進化する能力」は、生命のもっとも本質的な特徴の一つである。
さらにウイルスは、生態系に深く組み込まれている。細菌やアーキアの集団動態を制御し、海洋の物質循環に影響を与え、時には宿主の進化そのものを方向づける。もし生命を「地球上のシステムを動かす存在」と捉えるなら、ウイルスを生命から完全に切り離すことは、ますます困難になる。
ここで浮かび上がるのは、「ウイルスは生命ではない」という答えが誤りだというよりも、その問いの立て方自体が限界に達しているのではないか、という疑問である。
「ウイルスは生命か、否か」。この問いは一見明快だが、実はある前提を無意識のうちに含んでいる。それは、「生命とは細胞である」という前提である。細胞を基準に生命を定義すれば、ウイルスが外に置かれるのは当然である。
しかし、もしこの前提そのものを問い直したらどうだろうか。生命を特徴づけるものは、細胞という構造そのものではなく、自己を複製し、情報を継承する仕組みではないか。そう考えたとき、生命は「形」ではなく「情報を担う原理」として捉え直される。
この視点の転換によって、問いは「生命か否か」という二者択一から解放される。重要なのは、生きているかどうかを判定することではなく、「どのような自己複製システムをもつ存在なのか」を理解することになる。
この地点で、ウイルスはもはや生命の周縁的存在ではない。むしろ、生命という概念を拡張するための鍵となる存在として、正面から捉え直されることになる。
この問いの転換を明確な理論として提示したのが、巨大ウイルスを発見したディディエ・ラウールと分子生物学者のパトリック・フォルテールである。彼らは生命を「細胞をもつかどうか」ではなく、「何をコードしているか」という観点から再分類することを提案した。(2)
その結果、生命は大きく2つの原理に分けられる。1つは、リボソームをコードする生命体である。これは細菌、アーキア、真核生物を含み、タンパク質合成装置を自らの遺伝情報の中に持つ存在である。3ドメイン論が描いたのは、まさにこの生命体群の進化史である。
もう一つが、カプシドをコードする生命体である。ウイルスは、自らの遺伝情報を包み、伝達するための構造――カプシド――をコードする。彼らにとって重要なのは、細胞を作ることではなく、情報を保存し、次世代へ運ぶことである。
ここで重要なのは、ウイルスが「生命から排除された」のではなく、「異なる生命原理に基づく存在」として位置づけ直された点である。
この視点に立つと、3ドメイン論の意味も新たに見えてくる。3ドメイン論は、生命のすべてを網羅する理論ではない。それは、「リボソームをコードする生命体」がどのように分岐し、多様化してきたかを描いた理論なのである。
したがって、ウイルスが3ドメインに含まれないことは欠陥ではない。むしろ、3ドメイン論がどこまでを説明し、どこから先は別の原理が必要なのかを明確に示している。
この再解釈によって、細胞生命とウイルスは対立的な関係から解放される。両者は異なる原理に基づく存在でありながら、進化の歴史の中で深く結びついてきたのである。
こうした整理をさらに揺さぶったのが、巨大ウイルスの発見である。巨大ウイルスは、従来のウイルス像を超える大きさと遺伝子数を持ち、タンパク質合成やDNA修復に関わる遺伝子を含むこともある。
これらの特徴は、「ウイルスと細胞生命のあいだには明確な壁がある」という考えを難しくする。両者のあいだには、断絶ではなく連続的な勾配が存在するように見えるのである。
ただし、巨大ウイルスは細胞になる途中段階の存在ではない。彼らはあくまでカプシドをコードする生命原理に属しつつ、その内部で多様な進化を遂げてきた存在である。この点を理解することで、境界の「ゆらぎ」は混乱ではなく、生命の多様性の表現として捉えられる。
とりわけ示唆的なのが、アーキアウイルスの存在である。多くのアーキアウイルスは、宿主アーキアの中で、ピラミッドのような構造を作り、細胞壁に穴を開けて放出される。宿主を溶かして破壊するのではなく、非溶解的に放出され、長期的に共存する。(9)
このウイルス関連ピラミッド(Virus Associated Pyramid:VAP)に代表されるように、アーキアウイルスと宿主は単純な加害者と被害者の関係ではない。両者は極限環境という厳しい条件のもとで、互いに適応し合いながら生態系を維持している。
この共存関係は、ウイルスを「敵」としてのみ捉える生命観の限界を示している。ウイルスは、生命システムの外部から侵入する異物ではなく、その内部に組み込まれた構成要素なのである。
文献
1. 山内一也:ウイルスと地球生命、2012.
2. 山内一也:ウイルスの意味論,みすず書房、2018.
3. Forterre, P.(Translated by Fagan, T.L.): Microbes from Hell. The University of Chicago Press, 2016.
4. Zillig, W. et al.: DNA-dependent RNA polymerase from the Archaebacterium Sulfolobus acidocaldarius. European Journal of Biochemistry, 96, 597-604, 1979.
5. Woes, C.R. et al. : Towards a natural system of organisms: proposal for the domains Archea, Bacteria, and Eucarya. Proceedings of the National Academy of Sciences, USA. 87, 4576-4579, 1990.
6. Pace, N.R. et al. : Phylogeny and beyond: Scientific, historical, and conceptual significance of the first tree of life. Proceedings of the National Academy of Sciences USA, 109, 1011-1018, 2012.
7. Yeats, S. et al.: A plasmid in the archaebacterium Sulfolobus acidocaldarius. The EMBO Journal, 1, 1035-1038, 1982.
8. Chibani, C.M. et al.: Inaccurate viral prediction leads to overestimated diversity of the archeal virome in the human gut. Nature Communications, 15, 5976, 2024.
9. Kuiper, B.P. et al. : Archael virus entry and egress. microLife, 5, 1-13, 2024.
II 殺さない感染——極限環境を生きるアーキアウイルス
非溶解的共存という戦略
ウイルスはなぜ宿主を壊すと考えられてきたのか。
20世紀のウイルス学は、「感染とは破壊である」という直観に支配されてきた。細菌ウイルス(ファージ)による溶菌斑(プラーク)、動物ウイルスによる細胞変性効果――それらは、ウイルスを宿主を殺して増える存在として可視化した。この視覚的経験は、ウイルス=捕食者、宿主=犠牲者という物語を半ば自明のものにした。しかしこの物語は、すべての生命圏に普遍的なのだろうか。
1982年、別府温泉の高温(約80℃)・強酸性(pH2–3)の環境から、超好熱性アーキア(古細菌)のスルフォルブスと、それに感染するウイルスが見つかった。このウイルスは、紡錘形(スピンドル型)という特異な形態をもつことから、スルフォルブス・スピンドル型ウイルス(SSV)と名づけられた。超好熱性アーキアに感染するウイルスは、その後、世界各地の火山温泉など極限環境から次々と分離されている。
スルフォロブス属アーキアに感染するウイルスは、感染したアーキア細胞を溶かさない。細胞は分裂を続け、代謝も維持される。その細胞表面には、やがてピラミッド状の構造体が形成される。この構造はウイルス関連ピラミッド(VAP: Virus-Associated Pyramids)と呼ばれ、細胞膜を破壊することなく開閉し、開口部からウイルス粒子を外界へと放出する。開口部は小さく、細胞そのものは致命的な損傷を受けない。
図 SSV接種アーキア細胞に見られるVAP形成からウイルス放出まで
A:接種0.5時間後 B:接種3-6時間後、矢印はVAP C:接種9時間後
接種12時間後。ウイルス粒子(オレンジ色と紫色の棒、VAP(黄色) 文献1
ここでは感染は死を意味しない。むしろウイルスとアーキアは、同じ細胞を共有しながら、時間の中で関係を持続させている。
この現象を理解する鍵は、生態学的制約にある。極限環境では宿主であるアーキアの密度が低く、ウイルスが新たな宿主へ再感染する機会は限られている。宿主を殺せば、ウイルス自身の存続基盤が失われる。したがって、溶菌しないことは「弱さ」ではなく、選択された生存戦略なのである。
ここで「感染」という言葉の意味が反転する。それは侵略ではなく同居であり、破壊ではなく調整である。
アーキアのゲノムには、過去に感染したウイルスの遺伝子配列が刻まれている。再び同じウイルスが侵入すると、その配列を手がかりにウイルスDNAを認識し、切断する仕組みが働く。この防御系はクリスパー・キャスナイン(CRISPR-Cas)*と呼ばれている。CRISPR-Casは、場合によってはウイルスを完全に排除するが、結果としてはウイルスと宿主の関係を断ち切るというより、長期的な共存関係を形成する方向に働くことが多い。そこでは一方的な排除ではなく、ウイルス量の制御を通じた均衡が保たれている。
(*ゲノム編集技術は、アーキアで見つかったクリスパー・キャスナイン・システムを応用したものである。)
このような非溶解的関係は、極限環境に特有の例外的現象なのだろうか。むしろそれは、これまで見過ごされてきただけで、生命圏全体に潜在的に存在する関係様式なのかもしれない。宿主を即座に破壊することだけが、感染の唯一の帰結ではない。
この非溶解的共存は、ウイルス観だけでなく、生命観そのものに問いを投げかける。生命を「個体の自己完結性」で定義するなら、ウイルスは周縁的存在にとどまる。しかし生命を「情報と代謝が結びつき、時間的に持続するプロセス」と捉えるなら、ウイルスはその内部に深く組み込まれている。
極限環境のアーキア世界が示すのは、生命は必ずしも勝利を選ぶのではなく、続く関係を選ぶという事実である。ウイルスは敵ではない。生命系の調律者として、進化の速度と方向を静かに制御する存在なのである。
文献
1. Datum, B. et al.: Self-assembly of the general membrane-remodelling protein PVAP into sevenfold virus-associated pyramids.l Proceedings of the National Academy of the Sciences, USA, 111, 3829-3834, 2014.
2. Kuiper, B.P. et al. : Archael virus entry and egress. microLife, 5, 1-13, 2024.
スポット法とプラーク法——同じ円、逆の意味
同じ寒天平板に現れる、同じ円形の斑点が、まったく逆の意味を持つことがある。プラーク法とスポット法は、ウイルスと生命の関係を正反対の方向から可視化する。
動物ウイルスと細菌ウイルス(ファージ)で用いられるプラーク法では、寒天平板上に均一に広がった宿主細胞層の中に、ぽっかりと抜け落ちた円形の斑点が現れる。そこではウイルスにより細胞が殺され、剥がれ、消えている。プラークとは、細胞死の痕跡である。
アーキアウイルスではスポット法が用いられる。溶かした寒天に宿主であるアーキアを混和して平板化する。6〜12時間、予備培養してアーキアの芝生が薄く見え始めた段階で、ウイルスを滴下して24〜72時間培養すると、ウイルスは寒天中を円形に拡散する。芝生が厚すぎるとウイルスの拡散が阻害されて円の境界がぼける。成長中の細胞または分裂・定着が不安定な段階にウイルスを感染させなければいけない。成長が止まった細胞は、ウイルスと相互作用する余地を失っているからである。未感染あるいは不適切な感染状態にある細胞の方が、むしろ寒天から剥離して失われる。円形の芝生はウイルス拡散と細胞増殖の競争の結果として表れる。
スポット法で観察される円形の斑点は、プラーク法の場合と同じ幾何学を持ちながら、まったく逆の意味を帯びる。寒天上に残るのは、透明な穴ではなく、むしろ黒く濃い円形である。そこには細胞が存在し、寒天にとどまり、生き残っている。
形は同じ円である。だが、その円が指し示す生命の状態は正反対である。この違いは、まず物理法則に由来する。いずれのアッセイでも、ウイルス粒子は寒天中の一点から拡散する。寒天は固体ではなく、分子が移動可能なゲルであり、拡散は等方的に進む。濃度の等値線は円となり、ある閾値で細胞の運命が分かれる。その結果、境界としての円が可視化される。
しかし、その内側で起きている生物学は根本的に異なる。動物ウイルスにとって感染とは、細胞変性効果を引き起こし、宿主を破壊する過程である。細胞は剥がれ落ち、染色される対象が消失する。円は「不在」を示す。
一方、多くのアーキアウイルスは、宿主を即座には殺さない。非溶菌的な放出、溶原化、あるいは増殖抑制型の感染を通じて、宿主細胞は生きたまま寒天中に残る。未感染あるいは不適切な感染状態にある細胞の方が、むしろ寒天から剥離して失われる。その結果、円の内側には細胞が“残存”し、光を散乱させ、黒く見える。
ここで可視化されているのは、細胞死ではなく、生存戦略である。同じ円形は、動物ウイルスにおいては「破壊の幾何学」であり、アーキアウイルスにおいては「共存の幾何学」である。円は普遍的な物理の産物だが、その意味は、生物の進化史によって反転する。
極限環境に生きるアーキアと、そのウイルスにとって、宿主を即座に殺すことは必ずしも有利ではない。限られた環境で持続的に存在するためには、破壊よりも調整が選ばれる。黒い円は、その進化的選択の可視的な痕跡なのである。
プラーク法とスポット法。同じ円を描きながら、語っている生命観は正反対である。その逆転こそが、ウイルスという存在が、単なる病原体ではなく、生命のあり方を映す鏡であることを教えてくれる。
両者の円形は、寒天中におけるウイルス粒子の拡散という同一の物理法則から生じる。しかし、その内側で起きている生物学は正反対である。プラークの円は破壊の幾何学であり、スポットの円は共存の幾何学である。同じ形が、異なる進化史と生命戦略を映し出している。
図 プラーク法とスポット法
プラーク法:寒天平板上に形成された均一な宿主細胞層の中に、透明な円形の斑点(プラーク)が現れる。プラーク内部ではウイルス感染によって細胞が破壊・剥離し、細胞が「存在しない」状態が可視化されている。円は細胞死の痕跡である。
スポット法:成長途中のアーキアを含む寒天平板上にウイルスを滴下すると、ウイルスは寒天中を等方的に拡散し、円形の領域が形成される。ここでは宿主細胞は溶菌されず、生きたまま寒天中にとどまり、光を散乱させるため黒く濃い円として観察される。円の内側は細胞の「不在」ではなく、「残存」を示す。
III 制圧から、関係の設計へ——生命とは、続く関係である
人間は長いあいだ、病原体との関係を「戦争」として描いてきた。
細菌やウイルスは敵であり、見つけ次第、排除すべき存在である。消毒、殺菌、撲滅――近代医学と公衆衛生は、この発想によって大きな成果を上げてきた。それは歴史的事実であり、否定されるべきものではない。
しかし21世紀に入り、その限界もまた、はっきりと見え始めている。新興感染症の多くは、人間社会の内部だけで完結しない。野生動物、家畜、土地利用、気候変動といった要因が重なり合い、その結果として人間の健康問題として現れる。感染症は、外から侵入してくる単純な「敵」ではなく、複雑な関係の乱れが表面化した現象なのである。
こうした認識から生まれたのが One Health という考え方である。One Health は、人間の健康、動物の健康、環境の健全性を切り離さず、ひとつの連続したシステムとして捉えようとする枠組みである。この概念は、世界保健機関(WHO)、国連食糧農業機関(FA0)、世界動物保健機関(WOAH) などが連携して推進してきたもので、現代の感染症対策や環境政策の基盤となりつつある。
重要なのは、One Health が単なる政策スローガンではない点である。それは、人間を生態系の外に置く見方を改め、生命を関係性の中で理解し直そうとする思想でもある。人間の健康は、動物や微生物、環境の状態と切り離せない。ウイルスは「侵入者」ではなく、その関係がどこかで歪んだことを示す指標として現れる。
さらに近年では、この枠組みを一歩進めた One Welfare という考え方も注目されている。One Welfare は、健康だけでなく「福祉」や「幸福」という視点を含み、人間、動物、環境のウェルビーイングを総合的に考えようとする概念である。家畜の飼育環境、野生動物との境界、人間社会の生活様式――それらは互いに影響し合い、結果として健康リスクや倫理的問題を生み出す。
ここで、極限環境におけるアーキアとウイルスの関係が、思いがけない示唆を与える。そこでは、完全な排除は成り立たない。宿主を殺し尽くせば、ウイルス自身も生き延びられない。かといって、ウイルスの活動を完全に止めることもできない。両者は、過酷な条件のもとで、きわめて微妙な均衡点を選び取っている。
この姿は、人間社会における感染症対策とも重なる。制圧一辺倒の戦略は、短期的には成功しても、長期的には新たな問題を生むことがある。過度な抗菌・抗ウイルス対策は、微生物叢や生態系のバランスを崩し、別のリスクを呼び込む。極限環境のウイルス学が示すのは、「排除」ではなく「制御」や「共存」という現実的な選択肢である。
One Health / One Welfare は、こうした発想を社会に実装しようとする試みと言える。人間の健康を守ることは、動物や環境を犠牲にすることと同義ではない。むしろ、関係性を丁寧に設計し直すことこそが、持続的な健康と福祉につながる。ウイルスは敵であると同時に、生態系の一部でもある。その二面性を直視することが、現代の生命観には求められている。
極限環境は、私たちから最も遠い場所にあるように見える。しかし、そこで営まれている生命のあり方は、人間社会が直面する課題を鋭く映し出している。アーキアとウイルスが示すのは、過酷な条件下でも成立する「関係の知恵」である。
One Health / One Welfare とは、その知恵を人間中心の世界観から解き放ち、地球規模の関係性として再構築しようとする思想なのである。